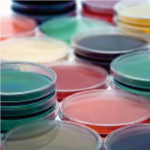
Hematologic testing image

OSR Mouse Clinic
The similarity of the mouse and human genetic make-up means that genes associated with disease in humans can be studied and further investigated in mouse models. Conversely, fundamental research using mouse models can identify genes associated with disease and provide insights into pathogenic mechanisms underlying environment-driven diseases, including infectious diseases and cancer. This knowledge can then be transferred to understanding and treatment of disease in humans. These properties justify the strategic relevance of mouse models of disease for the Institutional Research at the San Raffaele. However, mouse models are not always exact replicas of the human condition, and they are inadequate to study the onset and evolution of diseases that are caused by human-tropic infectious agents, such as HIV-1. Besides, common manipulations utilized by scientists in various fields to dissect the cellular and molecular basis of selected diseases make use of highly immunodeficient strains, whose reliability depends on the stringency of the SOPF measures adopted by local housing and breeding facilities.
The OSR Mouse Clinic (OMC) stems from the above rationale and is the follow-up and consolidation of a Regione Lombardia-funded project (EMDM), which aimed at the establishment and implementation of a large, dedicated facility (the European Mouse Disease Models Center) whose goal is the development and functional assessment of mouse disease models, both for the dissection of the underlying pathogenic mechanisms and for the screening and validation of innovative diagnostic and therapeutic procedures. OMC has been conceived to face the challenges posed by the development of mouse models of disease that are more reliable and display higher predictive value for the corresponding human condition. OMC has developed and standardized a coordinate set of activities, including the creation of a non invasive imaging facility, based on the acquisition of dedicated equipment (7-Tesla small bore MRI; micro-CT scanner; micro-US scanner; optical imaging scanner; micro-PET), the creation of a comparative pathology Unit and the implementation of a dedicated area for the use of mouse pathogens. OMC also aims at potentiating the existing Conditional Mutagenesis Facility by implementing novel approaches to attain tissue-, stage- and site-specific transgene expression in mouse mutant strains, mainly through lentiviral vector-mediated transduction of blastocysts.
A major asset of the OMC platform is the tight integration of preclinical scientists with physicians, who work side by side to comparatively assess pathogenic, diagnostic and therapeutic issues raised in patients with the mouse model counterpart.